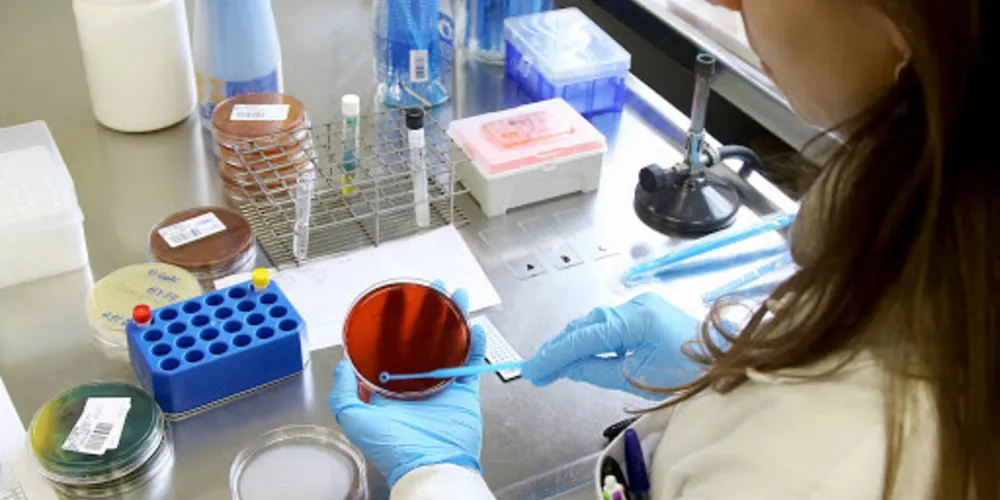
Município agora soma 530 casos confirmados da doença, com três óbitos

PG tem 26 novos casos de covid-19, aponta boletim
Além do terceiro óbito, confirmado neste sábado, município também registra mais um paciente internado na UTI
Além do terceiro óbito, confirmado neste sábado, município também registra mais um paciente internado na UTI
O boletim divulgado no início da noite deste sábado (4) pela Fundação Municipal de Saúde (FMS) aponta que Ponta Grossa registrou mais 26 pacientes diagnosticados com a covid-19 nas últimas 24 horas. Com isso, a cidade agora tem 530 casos confirmados, com três óbitos – o mais recente confirmado horas antes da divulgação do boletim.
Ainda conforme o documento disponibilizado pela FMS, o município tem três pacientes internados na Unidade de Terapia Intensiva (UTI) e outros quatro em leitos clínicos. São 128 pacientes recuperados e outros 392 em isolamento domiciliar. Ainda, mais de 3,1 mil pessoas são monitoradas por terem mantido contato com pacientes positivados e outros 11 pacientes internados sob suspeita de contágio pelo novo coronavírus.
Dos 20 leitos de UTI para atendimento exclusivo de pacientes suspeitos ou confirmados com a covid-19, no Hospital Universitário Regional dos Campos Gerais (HU-UEPG), 13 estão ocupados por pacientes de Ponta Grossa e de cidades atendidas pela 3ª Regional de Saúde – isso corresponde a uma taxa de ocupação de 65%.





















